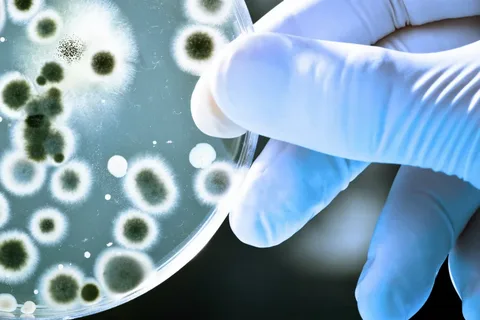

Protect Your Work as an Author & Creative
Premier legal registration services for authors, publishers, and creators — we secure your copyright, trademark, ISBN, and global rights so you can focus on creating.
Why Legal Protection Matters
Four visual panels or short sections explaining benefits:
Official recognition of ownership
Government-filed registrations
Lifetime and global protection
Peace of mind and credibility in the market
Each should include a link to “Explore Services.”

Why Professional Legal Protection Is Non-Negotiable
Four Pillars That Separate Protected Authors from Vulnerable Ones:
- Official Government Recognition
Your work receives an official, date-stamped federal registration — the single strongest evidence in any plagiarism or infringement lawsuit.
- Attorney-Handled Filings
We prepare and submit every document to the U.S. Copyright Office, USPTO, Library of Congress, WIPO, and WGA —zero headaches for you.
- Lifetime + Worldwide Enforcement Rights
Protection that lasts your entire life plus 70 years and is automatically recognized in 181+ countries — with optional strategic international filings for serious global players.
- Professional Credibility & Higher Earnings
Registered authors command bigger advances, better distribution deals, and instant legitimacy with agents, studios, bookstores, and streaming platforms.
Complete Intellectual Property Protection for Writers— Done for You
Choose the Package for the Author Legal Protection Your Work Demands
Basic Protection Bundle
Perfect for debut or first-time authors looking for U.S. Book Copyright Services, ISBN, LCCN & Barcode registration
Brand Builder Suite
For authors & creators building a recognizable name looking for Trademark Services for Authors, Trade Dress Protection, & Service Mark.
Global Creator Masterplan
For authors with film, franchise, or international ambitions looking for WIPO International Recordation.

As an academic and keynote speaker, protecting my intellectual property across books, online courses, and speeches is non-negotiable. The attorneys at American Author Board delivered comprehensive U.S. and international registrations with a level of precision and clarity I have never experienced with traditional law firms.
Dr. William Harris, PhD
Leadership Author & Speaker


I’ve self-published fourteen science-fiction novels. AAB set up my publishing LLC, filed my series trademark through the Madrid Protocol, and now my brand is protected in forty-seven countries. Worth every single penny for the peace of mind.
Steve Kunz
Clients


I received my copy today. Wow! Thank you so much for keeping the history of our town alive. You have awakened so many memories of my life in Summerfield! I highly recommend your book to everyone that has any connection with Summerfield and the surrounding area! Thank you again.
Marcus Reed
Science-Fiction Author & Publisher


My thriller just got optioned by a major studio. Because AAB had already registered my screenplay separately with the WGA and filed iron-clad copyrights, the producers told me my paperwork was the cleanest they’d ever seen. We closed the deal in eleven days!
Lina Chen
Screenwriter & Novelist


We create illustrated children’s books as a husband-and-wife team. AAB registered every character, every illustration, and even helped us trademark our little dragon mascot. Now we’re licensing plush toys and developing an animated series with zero fear. They genuinely feel like part of our creative family!
Emma & Noah Park
Children’s Authors & Illustrators